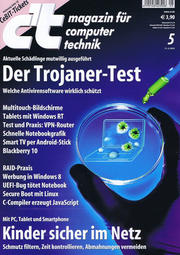

Inhalt
Hotspots sind zwar praktisch, wenn man unterwegs online gehen will. Doch wenn deren WLAN-Verbindungen unverschlüsselt sind, können Angreifer leicht vertrauliche Daten wie Passwörter ausspähen. Abhilfe ist einfach: Man leite Smartphone und Laptop aus dem Hotspot VPN-verschlüsselt über den eigenen vertrauenswürdigen VPN-Router ins Internet. Das Angebot an solchen Routern ist zwar überschaubar, aber durchaus den Anforderungen gewachsen.